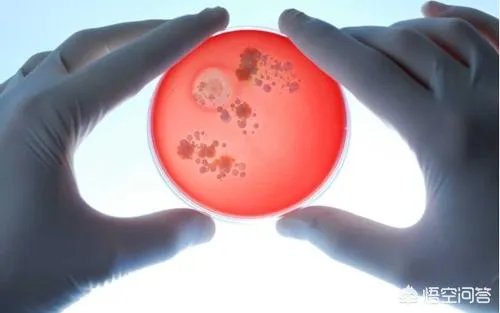
如果发现人类是高级文明培养实验品，会对现在社会有什么影响？

如果发现人类是高级文明培养实验品,会对现在社会有什么影响?
的有关信息介绍如下:其实从人类一直在思考看,这个问题已经不是问题。如果有人设计了人类,那又是谁设计了他们。这样反反复复的螺圈问题,是没有实际意义的。
我觉得还是老子在《道德经》里来得实在,从第二十五章的“道法自然”看,老子说的是“有物混成”,你看看,老子管这叫作“物”。
我还是认可霍金在《大设计》里的“它们(宇宙)的创生不需要某种超自然的存在或上帝的干预”。其实这句话用到这个问题上也是适用的。
人类社会的产生形成是自然发生的,不是上帝也不是什么高级文明培养的实验品。
这一点,中国先哲的认识是最高的。如道家的“我命在我不在天”、“与天地同寿、与日月同休”。
再从中国的“修真(仙)文化”看,相信人通过生命的修炼是可以升级的,也就是说人是可以和所谓的上帝平起平坐的,从这一点,是可以看出中国文明的价值的。
这些年通过对科学史的学习,还有很学者对西方文艺复兴和中国文化的比较研究看,我觉得是中国的世俗化影响了西方。以至尼采说出了“上帝死了”的名言。
而就这个问题,不又是回到有没有上帝的老路上去了吗。我认为这样的讨论是没有实际意义的。
与其去讨论这样的话题,还不让人类的文明等级升级来得实在。
努力学习,先将人类等级达到一级,再看看这个话题,再说吧。
“森林动物园”亦或是“生态观赏瓶”?
根据卡尔达肖夫宇宙文明等级的划分,知道宇宙文明等级可以有三个层次,且每一个新层次都是上一层次科技质变的结果,意思就是说,差一个等级,相当于差个十万八千里,而且每个大的等级又可以分为数个小的等级,目前人类文明勉强可以达到0.7级文明,距离迈入一级文明,还有相当长的路程。
人类文明的发展之路,特别像游戏中人物的升级之路,过程都是漫长且艰辛的。

那么宇宙中会不会存在一些已经发展数亿年之久的文明呢?是的,有这个可能存在,到了它们的那个高度,或许已经把宇宙走了个遍了,甚至还去别的宇宙“走亲戚”呢,人类在它们眼里,根本是看不到的存在。
不说那么高级的,说点相对高级一点的吧,比地球文明先进个一万年这样的文明,我想它们完成恒星际旅行应该没有什么问题,至少在星系的范围之内可以畅通无阻。

所以,高级文明在银河系内部还是存在的,并且数量还很多,它们来到过地球之上吗?
可能来过,不过只是稍作停留就匆匆离去了,因为它们不愿意在一群蚂蚁身上多浪费哪怕一秒,所以,说人类是高级文明的实验品,未免也太自作多情了。
趁着不被高级文明留意的这个节骨眼上,人类文明应当奋发图强,争取让它们也留意一下地球人类文明,如果它们想出手,那么打它们一个措手不及。

确实,有一种听起来让人感到毛骨悚然的观点,那就是我们之所以找不到外星人,是因为人类就是高级外星文明的“实验品”,也被称为“动物园理论”,地球就像一所“监狱”,而我们人类就是被外星人囚禁起来的“动物”!
甚至还有另外一种更加恐怖的观点,认为人类实际上生活一个虚拟的世界,完全是被一种神级外星文明模拟的世界,而我们每天感受到的真实其实只是一种错觉!
个人观点,与其相信这样的论调,宁愿选择相信人类是宇宙中的唯一智慧生命!不是说楼主提出的观点没有任何可能,就算是真实的,也许我们没有任何关系!
如果人类真的发现我们是实验品,可以说明以下几个问题。
一,即使人类是外星文明的实验品,但能够发现这样的事实,本身就说明人类科技也确实足够发达了,不然的话无论如何是发现不了的。
二,外星文明肯定更加发达,是我们人类科技无法比拟的!
三,由此带来一个问题,也可以说是悖论,如果说我们是外星文明的实验品,那理论上外星文明也会是某种文明的实验品……,最终陷入死胡同!
当然,如果发现了我们是外星文明的实验品,总的来说,我们也是无能为力!事实上,何不换一种思考方式,做一个比人类文明高出太多(甚至是神级文明)有何不好?人类历史上的很多神话故事讲述的不就是我们人类是他们的实验品吗?
就如同电影《盗梦空间》,就算是我们人类真的生活在所谓虚拟的世界,被神级文明模拟的世界,那又何妨?对于我们自己来说,我们就是生活在真真切切的世界里!
如果发现人类是高级文明培养实验品,会对现在社会有什么影响?

美剧《西部世界》某些方面就挺符合题主的设定,如今第二季已经出来了,人造人已经意识到自己是造物主的试验品,你可以去看看他们的社会出现了什么影响,这是编剧们的想象!
面对一个外星高级文明时人类社会会发生什么变化?刘慈欣的《三体》就描述过相关情节,书里关于人类社会降临派、拯救派的描写非常令人遐想,关于这个话题我也来开开脑洞吧:
第一:先分析分析人类是高级文明试验品的可能性有多大!
虽然产生生命的条件非常苛刻,但是宇宙这么大,各种星系、恒星、行星的数量数不胜数,我们的地球在整个宇宙当中并没有那么特殊,整个宇宙存在其它生命的可能性远大于我们是唯一生命的可能性,下图就是知名的德雷克方程。

虽然这个方程仅仅只是一种理论性的猜测,但还是很有道理的,不管你怎么去给各个参数取值,只要概率不是0,最终的结果也是一个比较大的数值,根据德雷克方程,有人推测仅仅银河系就有差不多1151个先进文明。

但是诺贝尔奖获得者,知名物理学家费米曾提出了一个非常经典的问题,这就是费米悖论,是啊,既然外星文明理论上有那么多,那么外星人在哪呢?为什么我们直到如今都没有发现它们?

关于费米提出的悖论,合理的解释可以是这样的:
一、宇宙中不存在别的文明,我们地球文明就是如此特殊!
二、外星文明是存在的(或曾经存在过),但它们迄今为止还无法和我们接触,有可能彼此的技术手段都没有发展到如此程度。
三、外星文明不仅仅存在,甚至外星文明都已经来过地球,只是我们不知道。
第三种可能性还是存在的,甚至有可能我们人类就是它们的试验品,我们之所以还没有发现它们,说到底还是因为它们有意识得干扰我们或者我们的观察能力太弱所致!我们人类培养的微生物未必知道我们的存在!从产生存在这种可能性的意识到观察出实实在在的结果,还有一段相当长的路需要走,这里面需要的技术提升幅度还是很大的!
根据我们人类现有的科技手段推测地球已经有46亿年的历史了,地球上的生命也已经存在三十多亿年,我们人类出现的历史也就几百万年,生命从何而来有许多谜团都很难解开,目前较为公认的地质年代与生物历史是这样的:

如果我们理解时间的本质是什么,就能够理解虽然看起来地球生命的历史很长,但是如果这个造物主具有超强的科技能力,这段历史对于它来说可能仅仅只是几天而已,相对论里有两个比较知名的效应,一个叫时间膨胀效应,一个叫引力时间延迟效应,这两个效应均可以解释这种可能性的存在!
1:时间膨胀效应:
这个效应是人类从宇宙射线中观察到的,根据相对论的解释,空间和时间的尺度会随着观察者速度的改变而改变,通俗得说如果这个外星人在地球投下试验品之后就坐在一架无限接近光速飞行的飞船里,我们地球时间虽然已经过去了几十亿年,这艘飞船上的时间有可能只是过去了短短一瞬!如今它还没有到下一次观测的时间!

2:引力时间延迟效应:
时间走得快慢与引力大小有一定关系,相对来说引力越大时间走得越慢!这个现象已经从宇宙当中观测到了,我们的宇宙学家通过分析整个宇宙的引力状况推测整个宇宙我们人类可以观察到的部分仅仅只有5%,剩余95%是由我们观察不到的暗物质和暗能量组成,前面提到的时间膨胀效应某种程度上来说也是引力作用的产物,接近光速飞行的飞船之所以能够产生时间延迟效应,也是因为这样的飞船具有极大的质量,内部产生了极大的引力!这个宇宙当中的暗物质或者暗能量会不会是这些高级文明的生存之地或者它们在活动的迹象?黑洞实际上就是个极强的引力场,黑洞内的时间与黑洞外是不一样的!

第二:再分析分析看假如我们人类已经观察到这是一个事实之后会怎么做?
首先我必须说这几乎无法想象,因为如果这真的是一个事实,说明这个造物主的科技水平之高已经超越现有人类的想象,它们的价值观也是我们难以想象的,我们对待它们的看法同它们对待我们的看法不会相同,也无法用我们现在看待微生物的感情去进行类比!
我们人类如果已经掌握观察到这个结果的能力,我们的科技水平与现在相比提升的肯定不是一星半点,科技水平不同人类族群的三观也会不同,现在我们的想象也只是基于如今人类现有三观基础上的联想而已!因为会怎么做,既是技术问题,更是选择问题,怎么选择核心还在于价值观!如果我们人类真的发现了这样一个事实,我可以说大家不会觉得很意外,因为这一切其实我们已经有了心理准备!这种发现都是循序渐进的,我们不会感觉很突然!

个人认为只要人类的基因不进行人为的修正,在做哪些选择方面多多少少会存在一些原始的逻辑在里面,人类族群内部应该还是会存在分歧,如下几种选择都会有人赞同:
第一类:顺其自然
顺其自然既是勇敢,也是懦弱,顺其自然往往是面对未知时最容易让人接受的一种选择,如果我们人类发现了这个事实,可能会选择既不主动去联系这个造物主尝试与它进行沟通,也不抵触它对我们的观察和影响,暂时先不去打破这个平衡,说到底就是当它不存在!从策略上来说以不变应万变有时候也是高明的!即使是选择出击,我们可能也会佯装不知道这一切迷惑对方,这样对方在明我们在暗,我们才有可能变被动为主动!
第二类:做出改变
个人认为选择视而不见的可能性是几乎为零的,就算是顺其自然也是在进行了解之后认为任何针对对方有意识的行动其实都是毫无意义时才可能做的选择,在刚开始发现这个事实时应该会采取如下行动:
第一步:进行进一步侦查
这种侦查行动的方式也会有许多种,既可以尝试直接与它们进行对话,也可以通过技术手段侧面观察了解,刚开始是敌是友不清楚的时候还是侧面侦查比较稳妥,不能打草惊蛇,侦查的主要目的是从两个方面了解对方,第一对方的技术能力是怎样的,通过这个评估对方对我们人类的威胁有多大,第二对方对待我们人类的态度是怎样的,对方对我们有什么企图?对方是敌是友?如果我们人类有一天真的发现了这样一个造物主,这个造物主的科技水平可能超过我们人类的想象,但也有可能已经被我们超越,各种可能性都有!

第二步:直接与它们进行正面接触
对它们有了一个基本状况了解之后肯定会尝试与其进行进一步接触,但是这个接触的目的就是五花八门了,因为我们人类族群内部很可能分歧还无法弥合,人类族群内部都是有可能分裂的,如果这个文明的科技水平远超我们人类,有的人会把它们看成救世主,有的人会将它们视作威胁,不同立场会产生不同的选择!
1:对人类失望并且把它们看成救世主的降临派会出现!
有些人对人类族群自身持悲观态度,很可能会对它们产生某种狂热的兴趣,会把它们当做拯救人类的救世主,这些人很可能会非常积极得同它们进行联系,并且表达自己希望救世主进行拯救的主张,希望它们对人类采取一些行动来解决你认为的一些问题!例如三体里的降临派就是这样的一个团体!
2:对人类没有失望将对方视作威胁的拯救派会出现!
我这里的拯救派并不是三体里拯救派的概念,三体的拯救派拯救的是三体人,实际上对待人类的态度与降临派半斤八两,我这里指的是人类自己的拯救派,如果你把它们看作人类的危险,并且对人类族群内部持积极乐观态度的,那么肯定会非常积极得准备进行防范,做好包括技术上方方面面的准备,如果持这种观点的人多我们人类会变得更团结,因为这关系到我们人类的生死存亡问题!

3:对方既不是救世主也不是威胁,最终找到共存之道!
这实际上是一种可能性的结果并不是刚开始主动的选择,在经过较为深入的接触甚至还产生过冲突之后,双方的力量如果相对均衡那么会进入这种亦敌亦友的平衡,就像世界上多出来一个大国一样,我们之间既会有合作也会有冲突,但更多的时候玩的是政治!

这个问题被他们知道了,不好,我说,文明还是用善恶来区分比较好,区分生命的是有机物和无机物,区分高级生命的是善恶,只有至善和至恶的两种生命才是高级文明,而地球就是善恶两种文明的角斗场,谁输谁赢还不知道呢。
人,生而平等的唯一,是"死亡倒数",也许長短不同,但公平的是没有人知是否下一刻。
每個人都知道"必死",可有真實使人恐慌?
如果知道"人是高级生物的實验品",猶如西方文化"上帝造人",猶太人中有部份是相信可反抗而不受上帝支配,有部份安份地做順民,不同的上帝信念可能會影响成不同的思想行為,但,具體的日常生活是否有影响?
编者的主題的答案,最好的觀察研究地,就是猶太人或基督教人群社會。
我的認知,一切事物,包括人,都是源於"大自然",如果有外星人,不論高矮智愚大或長腿,外星人也同样地,源出於大自然。
人類實驗室用细胞培養出的那隻羊,我的觀念,也不是人創造的,源出處,還是大自然。
你可能会有怀疑宇宙形成,你可能会怀疑人类活着的价值,你甚至会怀疑那些有神论的宗教信仰,甚至怀疑人类未来文明的走向。毕竟人类已经习惯了这种生物体的特性,和对整个宇宙物质的认识 ,这时你还会冒出另一大堆疑问,我们人类从哪里来?我们为什么活在地球上?外星人为什么不和我们接触?如果地球灭亡,人类毁灭,人类的灵魂将依附于何处?
假如,你养了一窝小白鼠,突然有一天它们的眼神里发现它好像若有所思,好像在质疑自己被圈养的命运,另外你发现,他们不但有想法,而且知道很多你才能理解的终极理论,仿佛随时有可能利用自己的“科技”挣脱你的束缚,从而了解整个事件的真相?然后,你怎么处理这窝小白鼠?
如果这培育长达数亿年,品种上千万类别,那样的话就算是培育也没啥好担心的,培育了地球不知道多少亿年才出人类了,现在你的生命就不到百岁,难道担心这百年会是这么多亿年的尽头么,更何况若有另外的智慧生命培育了地球这么多亿年,可以说是这培育内发展的好戏才刚刚开头呢,难道不更应该看下去?



